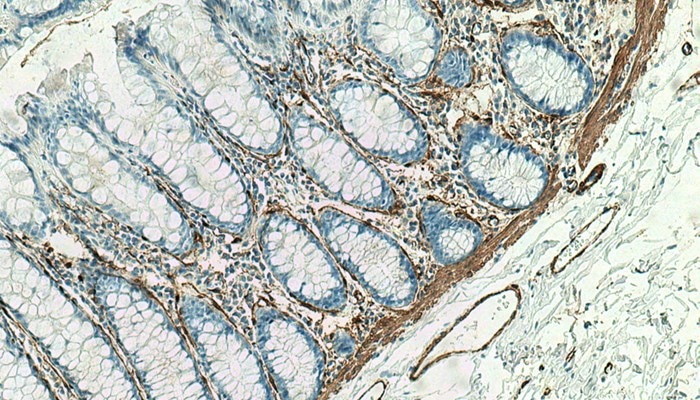

Use Able AI chat for product recommendations
Home / Video Hub
Videos
Introducing Able AI: The first AI-powered search tool for reagent selection and experimental design
Discover how artificial intelligence can revolutionize your lab workflow. In this webinar, we’ll explore how AI-powered tools can accelerate reagent selection and optimize experimental design through innovative 3D epitope mapping. This webinar will cover real-world examples to help you adopt these AI tools in your own workflows.
Western BlotView all
ImmunohistochemistryView all
ImmunoprecipitationView all
ImmunofluorescenceView all
 59:29
59:29
Meet the Expert: Dr. Indra Chandrasekar - Exploring the kidney cellular and organelle architecture using immunofluorescence imaging techniques
Technical TalkOtherView all
 1:04:32
1:04:32
Culturing Kidney Organoids: Best Practices for Differentiation and Long-Term Maintenance
Technical TalkFlow CytometryView all
Careers and LifestyleView all
Mini SymposiaView all
Proteintech PodcastView all

Able AI
I'm Able.
||
New chat
Able™
正在加载,请稍候...